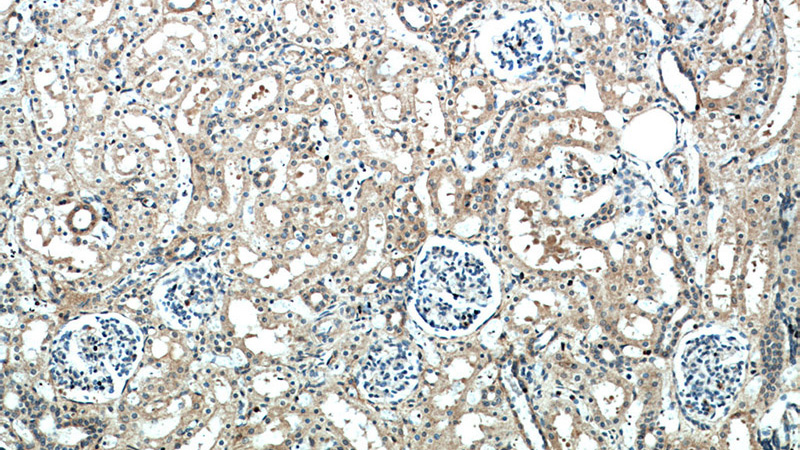
Immunohistochemical of paraffin-embedded human kidney using Catalog No:110721(FZD10 antibody) at dilution of 1:100 (under 10x lens)
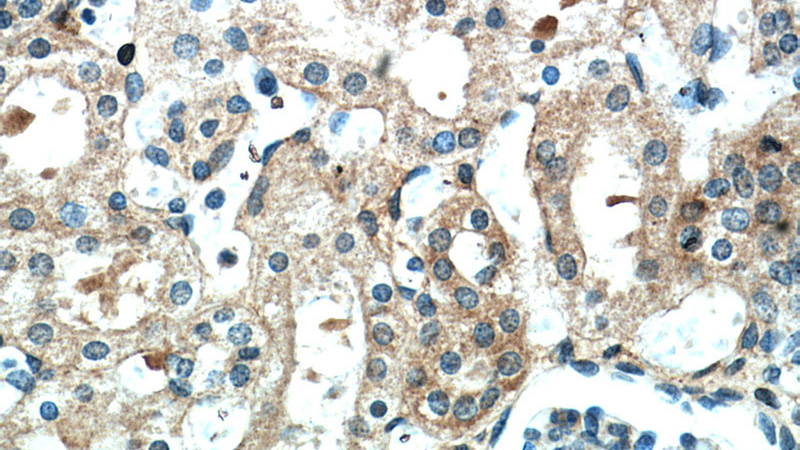
Immunohistochemical of paraffin-embedded human kidney using Catalog No:110721(FZD10 antibody) at dilution of 1:100 (under 40x lens)

-
Product Name
Frizzled 10 antibody
- Documents
-
Description
Frizzled 10 Rabbit Polyclonal antibody. Positive WB detected in mouse kidney tissue, HeLa cells. Positive IHC detected in human kidney tissue. Observed molecular weight by Western-blot: 65 kDa
-
Tested applications
ELISA, WB, IHC
-
Species reactivity
Human,Mouse,Rat; other species not tested.
-
Alternative names
CD350 antibody; Frizzled 10 antibody; FZ 10 antibody; FZD10 antibody; FzE7 antibody; hFz10 antibody
-
Isotype
Rabbit IgG
-
Preparation
This antibody was obtained by immunization of Frizzled 10 recombinant protein (Accession Number: NM_007197). Purification method: Antigen affinity purified.
-
Clonality
Polyclonal
-
Formulation
PBS with 0.02% sodium azide and 50% glycerol pH 7.3.
-
Storage instructions
Store at -20℃. DO NOT ALIQUOT
-
Applications
Recommended Dilution:
WB: 1:200-1:2000
IHC: 1:20-1:200
-
Validations

mouse kidney tissue were subjected to SDS PAGE followed by western blot with Catalog No:110721(FZD10 antibody) at dilution of 1:800
Immunohistochemical of paraffin-embedded human kidney using Catalog No:110721(FZD10 antibody) at dilution of 1:100 (under 10x lens)
Immunohistochemical of paraffin-embedded human kidney using Catalog No:110721(FZD10 antibody) at dilution of 1:100 (under 40x lens)
-
Background
FZD10 (Frizzled homolog 10) is a member of the frizzled gene family, and considered as a seven-transmembrane Wnt-signaling receptor. FZD10 is expressed at high levels on the cell surface of almost all synovial sarcoma tissues but absent in most normal organs except for placenta. Up-regulation of FZD10 mRNA in several types of human cells might lead to carcinogenesis through activation of the beta-catenin-TCF signaling pathway with some class of WNTs.
-
References
- Caron A, Xu X, Lin X. Wnt/β-catenin signaling directly regulates Foxj1 expression and ciliogenesis in zebrafish Kupffer's vesicle. Development (Cambridge, England). 139(3):514-24. 2012.
- Sun Q, Wang R, Luo J. Notch1 promotes hepatitis B virus X protein-induced hepatocarcinogenesis via Wnt/β-catenin pathway. International journal of oncology. 45(4):1638-48. 2014.
Related Products / Services
Please note: All products are "FOR RESEARCH USE ONLY AND ARE NOT INTENDED FOR DIAGNOSTIC OR THERAPEUTIC USE"
